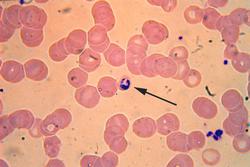

|
Parasitic
Protists
Parasite - an organism that
lives on or in a host organism and causes harm to that organism
Vector - an organism that can
carry a parasite, and is responsible for infecting other organisms (host)
with that parasite. Vectors themselves are not harmful, but in the battle
against human disease, controlling the vector can control the transmission
of parasites.
Malaria
Protist: Plasmodium
Vector: Anopholes Mosquito
Statistics:
- According to the World
Health Organization, 300-500 million cases of malaria occur each
year
- Malaria results in 1.5-2.7
million deaths per year (much more than AIDS)
- Most cases occur in Africa
and South America
- Symptoms include fever,
headache, vomitting and other flu-like symptoms
- The protist lives inside
the bloodstrea, eventually clogging capillaries and destroying blood
cells, which will lead to death if not treated
|
The arrow
points to the purplish colored protist (Plasmodium), the pinkish
spheres are blood cells
|

Anopheles
moquisto taking a blood meal, this is how a human becomes infected
with plasmodium and contracts Malaria
|
African Sleeping
Sickness (or Trypanosomiasis)
Protist: Trypanosoma
Vector: Tse Tse Fly
Statistics:
- Occurs mostly in sub-saharan
africa
- Symptoms include fever,
headaches, pain in joints -followed by a phase when the parasite infects
the central nervous system, causing confusion, lack of coordination,
and uncontrolled sleepiness. Without treatment, the host will die
|

This slide shows
a blood smear of a person infected with trypanosoma. The protist
is the purplish colored string-like things. They appear string-like
due to a flagella. The reddish circles are blood cells.
|
Giardiasis
Protist: Giardia
Transmission: Drinking contaminated water (usually outdoor streams and
other untreated water)
Symptoms: Severe diarrhea and vomitting, the protist takes up residence
in the digestive tract.
|
B
= Protist, Giardia
A = flagella
|
Other Protist Parasites
Cryptsporidium - this protist
was responsible for a major health crisis in detroit when the city's drinking
water became contaminated
Amebic Dysentery - also known
as Montezuma's Revenge, travellers often contract this in other countries
(causes diarrhea)
Questions for Thought
1. Does the United
States have a responsibility toward treating and containing parasitic
infections found in other parts of the world?
2. Why is controlling
the vector important to control the disease?
3. One of the best
ways to prevent many parasitic infections is to have a source of clean
water. Why do you think many third world countries have more incidence
of parasitic infection that other countries?
|